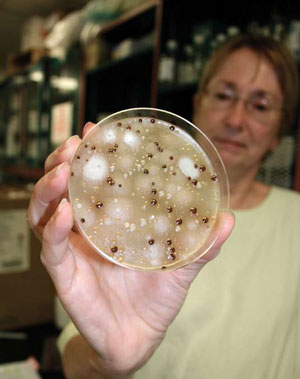

Mystery Disease Linked to Missing Israeli Scientist
H.P. Albarelli Jr
Media outlets across the Northwest United States began reporting on April 24 that a strange, previously unknown strain of virulent airborne fungi that has already killed at least six people in Oregon, Washington and Idaho is spreading throughout the region. The fungus, according to expert microbiologists, who have expressed alarm about the emergence of the strain, is a new genotype of Cryptococcus gatti fungi. Cryptococcus gatti is normally found in tropical and subtropical locations in India, South America, Africa and Australia. Microbiologists in the United States are reporting that the strain found here, for reasons not yet fully understood, is far deadlier than any found overseas.
Physicians in the Pacific Northwest are reporting that an undetermined number of people in the region are ill from the effects of the strange strain. Physicians also say that the virulent strain can infect domestic animals as well as humans, and symptoms do not appear until anywhere from two to four months after exposure. Symptoms in humans include a lingering cough, sharp chest pains, fever, night-sweats, weight-loss, headaches and shortness of breath. The strain can be treated successfully, if detected early enough, with oral doses of antifungal medication, but it cannot be prevented, and there is no preventative vaccine. Undiagnosed, the fungus works its way into the spinal fluid and central nervous system and causes fatal meningitis.
Physicians in the Pacific Northwest are reporting that an undetermined number of people in the region are ill from the effects of the strange strain. Physicians also say that the virulent strain can infect domestic animals as well as humans, and symptoms do not appear until anywhere from two to four months after exposure. Symptoms in humans include a lingering cough, sharp chest pains, fever, night-sweats, weight-loss, headaches and shortness of breath. The strain can be treated successfully, if detected early enough, with oral doses of antifungal medication, but it cannot be prevented, and there is no preventative vaccine. Undiagnosed, the fungus works its way into the spinal fluid and central nervous system and causes fatal meningitis.
The estimated mortality rate is about 25 percent of 21 cases analyzed. Several newspapers and media outlets in the US and overseas quote a researcher at Duke University's Department of Molecular Genetics and Microbiology, Edmond Byrnes, as stating: "This novel fungus is worrisome because it appears to be a threat to otherwise healthy people. Typically, we see this fungal disease associated with transplant recipients and HIV-infected patients, but that is not what we are seeing."
Microbiologists and epidemiologists studying the strain say the mystery fungus came from an earlier fatal fungus that was first found on British Columbia's Vancouver Island in the fall of 2001, and perhaps as early as 1999. There the fungus infected and killed dogs, cats, horses, sheep, porpoises and at least 26 people. The disease spreads through spores carried by breezes and wind and when people and animals encounter infected ground where the fungus is present. A number of microbiologists say that the disease has "the potential to essentially travel anywhere the wind or people can carry it." Reads an alarming study authored in part by Duke University's Edmond Byrnes: "The continued expansion of C. gatti in the United States is ongoing, and the diversity of hosts increasing."
Several researchers in California also note that the Cryptococcus gatti fungus has been researched for decades, extending back to the 1950's, at the US Army's biological warfare center, Fort Detrick, in Frederick, Maryland. One microbiologist at the University of California at Los Angeles recounted that the fungus was first brought to the attention of Fort Detrick researchers by British scientists experimenting with the bark of eucalyptus trees from Australia. Army biological warfare reports obtained through the Freedom of Information Act reveal that beginning around 1952 the Army mounted a huge research program involving numerous plant and fungi products, and that well over 300 long-term contracts and sub-contracts were let with over 35 US colleges and universities to carry out this multifaceted research. Examples of this early research in California included experiments and projects at Camp Cooke; Port Huemene; Harpers Lake; Oceanside, and extensive experimentation with wheat stem rust and "various spores" including "several from tropical locations" and cereal rust spores and dyed Lycopodium spores. Several Army reports reveal that private-sector corporations that participated or assisted in these projects were the American Institute of Crop Ecology; the American Type Culture Collection Inc.; University of California; Bioferm Inc. and the Kulijian Corporation.
The same microbiologist, who declined to speak on the record and who recounted extensive fungus work at Fort Detrick, also stated that researchers at Israel's Institute for Biological Research, located in Ness-Ziona about 20 km from Tel Aviv, have worked with the Cryptococcus gatti fungus. They also report that mysterious Israeli-American scientist Joseph Moshe, 56 years old, may have conducted covert studies with the fungus while he was recently living in California. This report concerning Moshe is especially interesting because Moshe was briefly in the international spotlight in 2009 when he was the subject of a spectacular chase and arrest by the LA police department and SWAT team, assisted by the FBI, Secret Service, CIA, US Army and several other unidentified federal officials. That highly unusual arrest has never been fully explained to the media, and the whereabouts of Moshe has remained unknown since its occurrence.

Compounding the mystery surrounding the Moshe case is that there is another scientist named Moshe Bar-Joseph who works in Israel and who looks remarkably like Joseph Moshe [see above pictures], except that he is about 20 years older.
Why Moshe was pursued and apprehended by the police is a largely unanswered question. According to the Los Angeles media, which recorded the entire incident by helicopter and ground cameras, Moshe claimed to be "a former Mossad microbiologist" who had telephoned a police dispatch number before his pursuit and had made "threatening statements about the White House and the president." Reportedly, Secret Service spokesman Ed Donovan confirmed this when he spoke with several Los Angeles reporters.

On August 14, 2009, several Los Angeles police cruisers and an unmarked armored vehicle pursued Joseph Moshe as he drove his red VW automobile [above] several miles through downtown Los Angeles before his car's engine was reportedly knocked out by an electromagnetic pulse. Moshe refused to exit his car when ordered several times by the police, and after the driver's window of his VW was smashed out by a robotic arm and several rounds of tear gas and pepper gas were fired into the vehicle, he still remained behind the wheel, refusing to move. At the time, police officers on the scene were stunned that Moshe was able to withstand three tear gas shells and hosing with pepper spray without moving. Later that day, a Los Angeles law enforcement official said: "I can't explain that; there's no way to explain that."
After his apprehension, Moshe was taken to the Patton State Mental Hospital and then to the Twin Towers Correctional Facility in Los Angeles. Sometime about 60 days later, Moshe was quietly released and his current whereabouts are unknown. Since his arrest became public, reports about Moshe's activities in the US have spread like wildfire, especially across the Internet. Many of these reports are unconfirmed, but a few come from credible sources and have linked Moshe to the grossly underreported outbreak of flu in the Ukraine.
Other reliable sources, including two former Fort Detrick biochemists, have also linked Moshe to a mysterious disease that is becoming alarmingly common in Vermont and other states, including California. The disease is known to have killed or incapacitated at least 10 to 20 rural dwellers and farmers. This disease is said to be Morgellons disease or "a rare, mutated form of Morgellons disease." Former Fort Detrick scientists, speaking off the record, say that the disease is one that was "experimented with intensely" in the late 1960's at several "test sites in New England." Morgellons causes patients to suffer horrible skin problems as well as fatigue, confusion and serious memory problems, as well as joint pain and the strange sensation that pins and needles are piercing the body or that something is crawling beneath one's flesh. Some researchers and physicians believe that Morgellons is actually a psychiatric condition called "delusional parasitosis." Other physicians, who are familiar with treating the disease, say it may be caused by "an airborne, unidentified spore" and that it was developed in the laboratory from an affliction that was first identified in the 1700's. Regardless of its origin, some researchers say that Morgellons is becoming "a very real medical problem in some parts of the country."
http://www.viewzone.com/israelifungus.html
